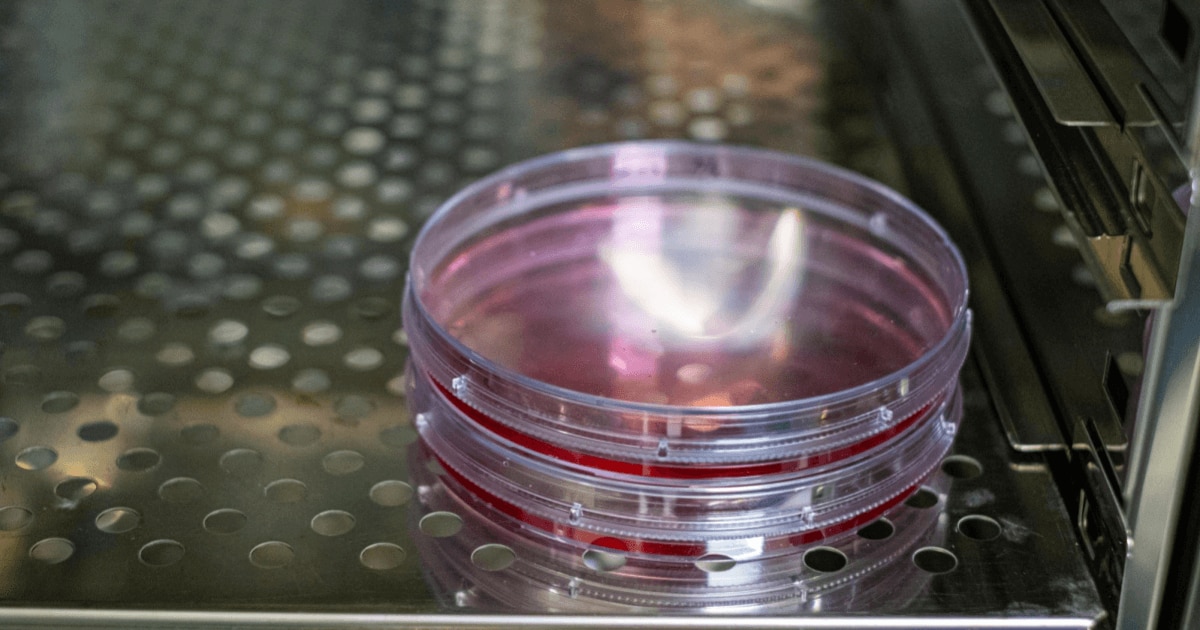
catch-img

細胞培養シャーレ(ディッシュ)とは? 主な種類と容器の選び方を解説
細胞培養を行う上で欠かせない器具のひとつが細胞培養シャーレです。研究室や実験施設ではごく当たり前のように使用されている容器ですが、その材質や構造、サイズによって用途や使い勝手が大きく異なります。
この記事では、細胞培養シャーレの基本的な定義や代表的な種類とサイズ、代替培養容器との違いについて解説します。
マイクロプレートのサンプルの取り寄せについてはこちらからお問い合わせください。
目次[非表示]
- 1.細胞培養シャーレとは
- 2.細胞培養シャーレの種類
- 2.1.材質による分類
- 2.1.1.ポリスチレン製(PS)
- 2.1.2.ガラス製
- 2.2.構造・機能による分類
- 2.2.1.ベントキャップ付きシャーレ
- 2.2.2.グリッド付きシャーレ
- 2.2.3.低接着性シャーレ
- 2.3.サイズバリエーション
- 3.細胞培養シャーレのサイズ比較表
- 4.細胞培養に使用するシャーレ以外の培養容器
- 4.1.細胞培養フラスコ
- 4.2.チャンバー付きカバーグラス
- 4.3.マイクロプレート
- 5.まとめ
細胞培養シャーレとは
細胞培養シャーレとは、細胞を無菌的かつ安定した環境で増殖させるために用いられる円形の培養容器です。
▼細胞培養シャーレの特徴
無菌性:γ線滅菌や電子線滅菌が施され、開封後すぐに使用可能
透明性:光学顕微鏡や蛍光顕微鏡での観察に適した高い透明度
表面処理:接着性細胞のための親水化処理やコーティング加工
ガス交換性:CO₂やO₂の交換を適度に行えるフタデザイン
細胞は環境変化に敏感であり、表面の性質やガス交換効率が培養結果に大きく影響します。例えば、一般的な接着性細胞には親水化処理済みのポリスチレン製ディッシュが用いられますが、浮遊系細胞や球状コロニー形成を観察する場合には低接着性のディッシュが適しています。
一見、細胞培養シャーレは単純な実験器具のように見えます。しかし、材質や構造に工夫が凝らされており、研究の効率性と再現性を支える基盤として重要な役割を担っています。
細胞培養シャーレの種類
細胞培養シャーレにはさまざまなバリエーションがあり、材質・構造・サイズによって分類されます。
材質による分類
細胞培養シャーレは主にポリスチレン(PS)製とガラス製に分かれます。日常的な細胞培養にはPS製、精密な観察や特殊実験にはガラス製といった使い分けが一般的です。
ポリスチレン製(PS)
もっとも一般的で、一次使用を前提としたディスポーザブルタイプです。透明性が高く、滅菌処理済みで開封後すぐに利用可能です。
ガラス製
耐薬品性に優れ、蛍光観察や共焦点レーザー顕微鏡観察に適しています。特に高解像度が必要なイメージングや、長時間のライブセル観察に利用されます。再使用が可能ですが、洗浄や滅菌処理が必要となるため、手間がかかる場合もあります。
構造・機能による分類
細胞培養シャーレは構造面でも多様化しており、実験の目的に応じて次のような選択肢があります。
ベントキャップ付きシャーレ
ガス交換を容易にするためのベント(通気孔)が付いており、CO₂インキュベーター内での培養に適しています。酸素や二酸化炭素の出入りを調整することで、細胞環境を安定させられます。
グリッド付きシャーレ
培養面にグリッド(格子)が印刷または刻印されており、細胞コロニーの位置特定やカウントを容易にします。クローニングやクローン選別の実験で重宝されます。
低接着性シャーレ
細胞が接着しにくい加工がされており、浮遊培養やスフェロイド形成、幹細胞研究に利用されます。3D培養を行いたい場合に適した選択肢です。
このような特殊機能付きディッシュは、従来の2D培養に加えて、再生医療やがん研究といった先端分野でも利用価値が高まっています。
サイズバリエーション
細胞培養シャーレには複数のサイズがあり、用途や培養規模に応じて使い分けられます。一般的なサイズと特徴は以下の通りです。
35mmシャーレ:少量の細胞観察や短期実験に最適
60mmシャーレ:中規模培養や複数条件の比較に最適
100mmシャーレ:大量の細胞を培養する際に用いられる標準サイズ
150mmシャーレ:スケールアップ培養や大量の試料を確保する必要がある場合に使用
研究のステージや必要な細胞数に応じて、これらを適切に選ぶことで、実験をよりスムーズかつ効率的に進めることができます。
細胞培養シャーレのサイズ比較表
細胞培養シャーレの代表的なサイズごとの特徴を以下で比較しています。サイズごとに培養面積・培養容量・適した用途が異なるため、目的に応じた選択が重要です。
サイズ | 培養面積(目安) | 培養容量(目安) | 主な用途 |
35mm | 約9 cm² | 1.8〜2.7 mL | 顕微鏡観察、小スケールの実験、条件検討 |
60mm | 約21 cm² | 4.2〜6.3 mL | 複数サンプル比較、短期培養 |
100mm | 約55〜57 cm² | 11〜17 mL | 標準培養、大量の細胞回収 |
150mm | 約148〜150 cm² | 29.6~44.4 mL | 大規模培養 |
細胞培養に使用するシャーレ以外の培養容器
細胞培養ではシャーレがもっとも一般的な容器として利用されていますが、研究の目的や細胞の特性に応じて、フラスコ・チャンバー付きカバーグラス・マイクロプレートといった代替容器が選択されることも多くあります。
細胞培養フラスコ
細胞培養フラスコは、シャーレと比較して長期培養や大量培養に適した容器です。ガス交換用のキャップが付いており、CO₂インキュベーター内で安定した環境を保ちながら細胞を増殖させることができます。
試料量が増加する実験や、大量のタンパク質やRNA抽出を行う際には欠かせない器具といえるでしょう。
チャンバー付きカバーグラス
チャンバー付きカバーグラスは、ガラス製のカバーグラス上に細胞を培養できる構造を持つ容器です。顕微鏡観察に最適化されており、特に蛍光顕微鏡や共焦点レーザー顕微鏡による高解像度観察に利用されています。
ガラス表面に直接細胞を培養できるため、蛍光標識されたタンパク質や細胞内小器官の挙動を高精細に追跡することができます。
マイクロプレート
マイクロプレートは、多数の小区画(ウェル)を持つ培養容器で、ハイスループット実験に最適です。96ウェルや384ウェルといった標準規格が用意されており、条件検討や薬剤スクリーニングを同時に行える点が大きな強みです。また、蛍光・発光アッセイとの相性が良く、レポーターアッセイや細胞イメージングにも活用されています。
マイクロプレートの詳細についてはこちらの記事で解説しています。併せてご確認ください。
まとめ
この記事では、細胞培養シャーレについて以下の内容を解説しました。
細胞培養シャーレの概要
細胞培養シャーレの種類
細胞培養シャーレのサイズ比較表
細胞培養に使用するシャーレ以外の培養容器
細胞培養は実験の基盤であり、適切な容器選びが研究成果の質を大きく左右します。
日本ゼオンでは『Aurora Microplates™︎』や細胞培養用オリジナルコートプレートなど、多様な研究ニーズに応える製品群も展開しており、研究者の実験環境をトータルでサポートしています。
実験の精度や効率を向上させる最新の情報や、詳細な仕様については、以下の資料からご確認ください。

